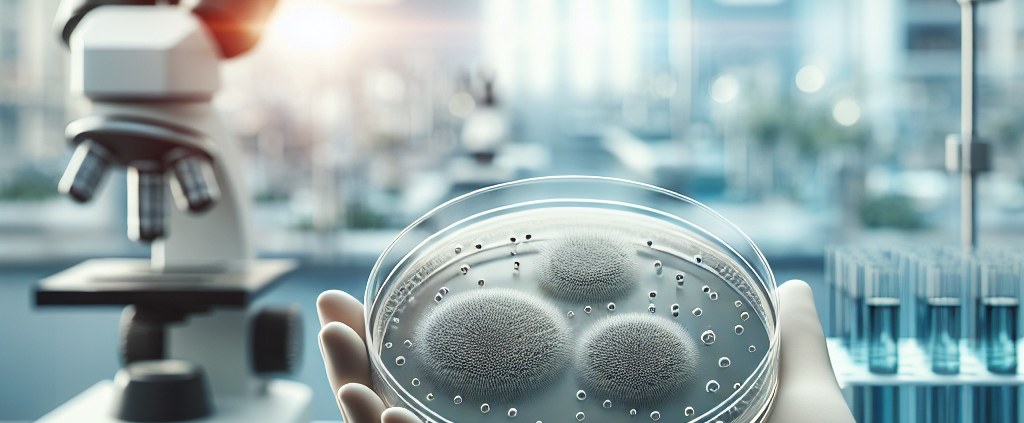

Microbiologie alimentaire : Nouvelles avancées sur la dynamique microbienne et la sécurité des aliments
Dynamiques des communautés microbiennes et sécurité alimentaire : avancées récentes en microbiologie alimentaire
Introduction
L'évolution de la microbiologie alimentaire a permis d'approfondir notre compréhension des communautés microbiennes, de leur dynamique et de leur impact sur la sécurité et la qualité des aliments. Les technologies de séquençage de nouvelle génération (NGS) ont franchi un cap, permettant l'analyse complexe des microbiotes alimentaires et la détection précise des pathogènes. Ces progrès facilitent le contrôle microbiologique tout au long de la chaîne alimentaire, de la matière première au produit fini, optimisant ainsi la sécurité et la conservation des denrées.
Progrès méthodologiques en microbiologie alimentaire
Utilisation du séquençage de nouvelle génération (NGS)
Le NGS, en séquençant l'ADN génomique total, offre un panorama exhaustif de la diversité microbienne. Il révèle aussi bien les micro-organismes dominants que les espèces rares ou émergentes, essentielles à la détection précoce des risques sanitaires. Cette approche permet :
- L'identification simultanée de multiples espèces microbiennes
- La différenciation des souches pathogènes et bénéfiques
- L'analyse des relations trophiques et écologiques au sein des matrices alimentaires
Métagénomique et bioinformatique
L'application de la métagénomique couplée à des outils bioinformatiques avancés permet de reconstituer la structure fonctionnelle des microbiotes alimentaires. Ces analyses facilitent la prédiction des interactions microbiennes, du métabolisme associé et des impacts potentiels sur la sécurité alimentaire. Les plateformes bioinformatiques caractérisent avec précision les communautés, guidant la mise en œuvre de pratiques de gestion du risque microbien.
Importance de la diversité microbienne dans les aliments
Rôle de la biodiversité dans la sécurité alimentaire
La diversité des communautés microbiennes influe directement sur la conservation et la sécurité des produits alimentaires. Une richesse spécifique accrue peut inhiber la prolifération de pathogènes via des effets de compétition et la production de composés antimicrobiens. L'analyse systématique de la diversité microbienne permet ainsi d'ajuster les étapes de transformation pour limiter la contamination ou l'altération.
Applications industrielles
- Fermentations contrôlées : l'ajustement ciblé du microbiote conduit à des fermentations plus sûres et plus stables.
- Amélioration de la qualité sensorielle : certaines communautés sont responsables de la saveur, de la texture et de l'arôme des aliments, tout en contribuant aux propriétés de conservation.
- Prévention des maladies d'origine alimentaire : l'optimisation du microbiote freine l'implantation des agents pathogènes tels que Salmonella, Listeria ou E. coli.
Influence des pratiques agricoles et industrielles
Effet des pratiques culturales
Les méthodes de culture, la sélection variétale et les traitements phytosanitaires affectent l’état initial des microbiotes, impactant la sécurité sanitaire en aval. Les pratiques agroécologiques favorisent, par exemple, le développement de communautés bénéfiques régulant la présence de contaminants.
Procédés de transformation
Des technologies comme la pasteurisation, l’irradiation ou la haute pression modifient considérablement les structures microbiennes. Il s’avère crucial d’analyser l’effet de ces traitements afin de conserver une microbiologie favorable tout en réduisant les risques.
Applications biotechnologiques et innovation
Contrôle biologique et biopréservation
L’introduction de cultures protectrices ou probiotiques répond à la nécessité de renforcer la sécurité et la conservation des denrées. Ces biotechnologies exploitent des bactéries ou levures sélectionnées pour leur capacité à limiter le développement des pathogènes.
Développement de nouveaux indicateurs de qualité
L’identification de biomarqueurs spécifiques par le séquençage permet de développer des outils de traçabilité et de diagnostic rapide, essentiels pour l’industrie agroalimentaire moderne.
Défis futurs et perspectives
La croissance rapide des bases de données microbiologiques nécessite d’affiner les analyses taxonomiques et fonctionnelles. L’émergence de la résistance aux antimicrobiens, la mutation des pathogènes et l’adaptation écologique soulèvent de nouveaux enjeux. Une surveillance continue, associée au partage de données et à la collaboration interdisciplinaire, reste incontournable pour anticiper les risques microbiens et assurer la sécurité alimentaire globale.
Conclusion
Les avancées récentes en microbiologie alimentaire, stimulées par les technologies de séquençage et les biotechnologies, transforment la gestion du risque microbien dans l’agroalimentaire. En renforçant la compréhension des dynamiques microbiennes, elles ouvrent la voie à des stratégies innovantes de sécurité, de traçabilité et de conservation des aliments.
Source : https://www.sciencedirect.com/science/article/pii/S0195666321006352